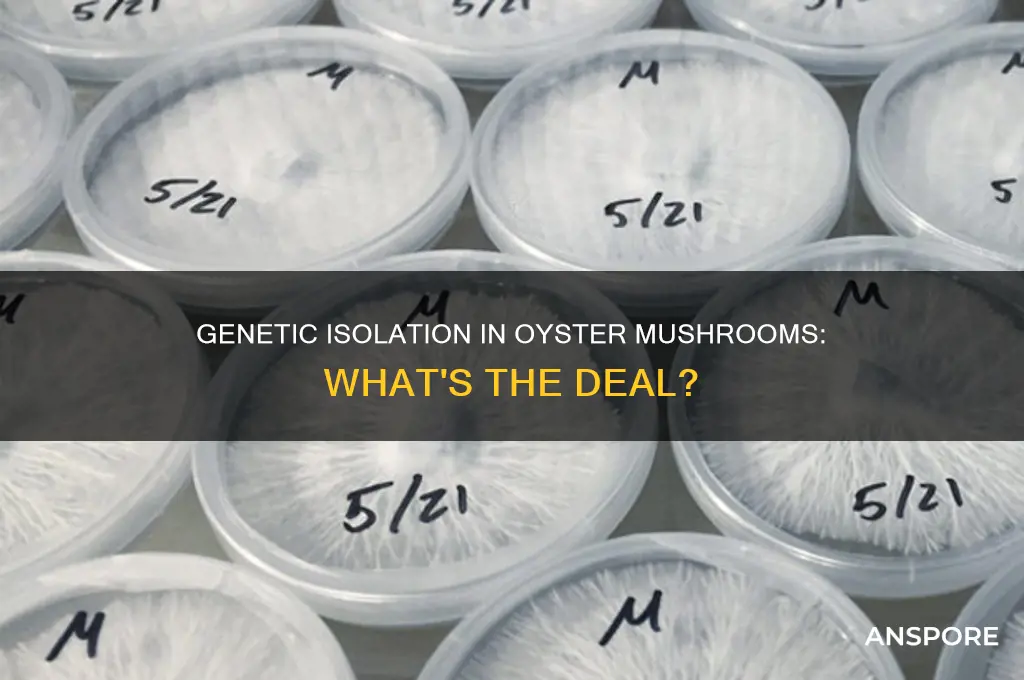
does genetic isolation occur between oyster mushrooms

Oyster mushrooms, belonging to the genus Pleurotus, are the second most cultivated mushroom globally after shiitake. They are grown commercially worldwide, especially in developing countries, for their ease of cultivation and high biological efficiency. Pleurotus cornucopiae is one of the main oyster mushroom species due to its gastronomic value and nutraceutical properties. Oyster mushrooms can be cloned or genetically isolated into pure cultures from the basidiocarp, and their genetic improvement has been achieved through direct selection and systematic breeding techniques. The isolation of genes expressed during the developmental stages of oyster mushrooms has been studied, and several genes involved in various physiological functions have been identified. Ancient and recent patterns of geographic speciation in oyster mushrooms have also been explored through phylogenetic analysis of ribosomal DNA sequences, revealing evidence of reproductive isolation and genetic divergence among different species.
| Characteristics | Values |
|---|---|
| Genetic isolation in oyster mushrooms | Ancient patterns of geographic speciation |
| Oyster mushroom species | Pleurotus cornucopiae, Pleurotus ostreatus, Pleurotus pulmonarius, Pleurotus eryngii, Pleurotus tuoliensis, Pleurotus djamor, Pleurotus cystidiosus |
| Oyster mushroom characteristics | High biological efficiency, gastronomic value, nutraceutical properties, rich in proteins, minerals, vitamins and fibers |
| Oyster mushroom cultivation | Widely cultivated, commercially worldwide, especially in developing countries |
| Oyster mushroom genetics | Genetic linkage and physical mapping, skewed segregation in homokaryotic offspring, genetic improvement through hybridization and mating |
| Oyster mushroom breeding objectives | Higher productivity, fruit body quality, sporelessness, resistance/tolerance to stresses, better shelf life |
| Oyster mushroom gene expression | Genes involved in fruiting body development, mating-type determination, mycelial growth, and physiological functions |
Explore related products
What You'll Learn

Oyster mushrooms can be cloned via pure culture isolation
To ensure successful cloning, it is recommended to use fresh mushrooms, as this increases the chances of success. Additionally, specific sterile practices and good crop management techniques are crucial for optimal results. The growing mycelium can be periodically transferred onto a fresh medium, and it is important to maintain careful culture storage to preserve the specific strain of oyster mushroom. The spawn is created by inoculating grain with mycelium from pure cultures, which can then be used for spawn production.
The process of cloning oyster mushrooms allows for the preservation of unique strains and the discovery of new varieties, contributing to the conservation of fungal biodiversity. It provides consistent and reproducible results, making it a valuable technique for growers seeking predictable outcomes while exploring mycology. Cloning oyster mushrooms can be achieved through careful methods and attention to sterility, making it a fascinating and versatile technique for growers.
Oyster mushrooms are particularly suitable for cloning, as they are easy to grow and adaptable to various conditions. They are known for their rapid colonisation, abundant fruiting, and tolerance of imperfect conditions. Additionally, oyster mushrooms are commercially cultivated worldwide due to their ease of cultivation and high biological efficiency. Cloning oyster mushrooms allows for the preservation and propagation of specific strains with desirable characteristics, ensuring consistent results in cultivation.
Portabella Mushrooms: Nutritional Powerhouses?
You may want to see also

Genetic linkage and mapping for Pleurotus cornucopiae
Oyster mushrooms, or Pleurotus, are commercially grown worldwide, especially in developing countries, due to their ease of cultivation and high biological efficiency. They are also a significant protein source for these countries. The two main species of oyster mushrooms produced and consumed are Pleurotus cornucopiae and Pleurotus ostreatus. They are distinct species despite their morphological similarities.
Pleurotus cornucopiae is one of the most important oyster mushroom species because of its gastronomic value and nutraceutical properties. Consumers prefer dark mushrooms, but they only make up a small portion of commercial varieties. This has led to a demand for breeding efforts to improve quality-related traits to satisfy consumers' preferences.
Genetic studies on P. cornucopiae have been limited, and fundamental knowledge about genome structure and the genetic basis for agricultural characteristics is lacking. However, a recent study by Zhang et al. (2021) constructed a saturated genetic linkage map of P. cornucopiae using a segregating population of 122 monokaryons and 3,449 single nucleotide polymorphism (SNP) markers. The map contains 11 linkage groups covering 961.6 centimorgans (cM) with an average marker spacing of 0.27 cM.
The genome of P. cornucopiae was de novo sequenced, resulting in 425 scaffolds (>1,000 bp) with a total genome size of 35.1 Mb. The scaffolds were assembled with the help of the genetic linkage map, and 97% of SNP markers were physically localized on 140 scaffolds assigned to 11 pseudochromosomes. Six quantitative trait loci (QTL) controlling cap colour in P. cornucopiae were identified, with the highest value found on pseudochromosome 5 (18%). This information provides a foundation for marker-assisted breeding for agronomic traits and studies on the biological mechanisms that control cap colour in oyster mushrooms.
The Ultimate Guide to Seasoning Shiitake Mushrooms
You may want to see also

Oyster mushroom species diversity and hybridization
Oyster mushrooms, scientifically known as the genus Pleurotus, are the second most commonly grown mushrooms in the world. They are well-known for their socioeconomic and biotechnological potential, as well as their nutritional and medicinal benefits. Pleurotus is an important genus comprising several edible species of great commercial significance. They are cultivated worldwide, particularly in developing countries, due to their ease of cultivation and high biological efficiency.
There is a huge strain and species diversity in the Pleurotus genus, with 26 taxa documented in India as of 2017. Some of the species include Pleurotus eryngii, Pleurotus ostreatus, Pleurotus pulmonarius, Pleurotus citrinopileatus var cornucopiae, Pleurotus djamor, and Pleurotus florida. The genetic improvement of oyster mushrooms has been achieved through various breeding approaches, including selection, hybridization, mutation breeding, molecular breeding, and genetic transformation.
Hybridization plays a crucial role in the genetic improvement of oyster mushrooms. Intraspecific hybridization, also known as mon–mon or mono–mono hybridization, occurs between compatible monokaryons from different strains of the same species. This results in the production of a dikaryon. Dikaryotization, the conversion of a homokaryon into a dikaryon, can be achieved through the fusion of compatible homokaryons or the fusion of a monokaryon with another dikaryotic mycelium. Di-mon mating is a type of hybridization that occurs between a dikaryon and a monokaryon, regardless of their mating types.
The selection of diverse parents producing basidiospores is critical for successful hybridization. Single spore isolates (SSIs) selection is another important factor for economically important traits such as yield. In addition, the mating system of oyster mushrooms is heterothallic, requiring two different compatible mating types to initiate the reproductive phase. This heterothallic nature contributes to the enormous diversity observed in oyster mushroom species.
The genetic diversity within oyster mushroom species has been studied in various regions, including Kenya, where three mushroom species (P. djamor, P. floridanus, and P. sapidus) were identified within the diversity of Pleurotus species in the country. The mean genetic diversity among the Kenyan populations was 0.25, with the Arabuko Sokoke population having a slightly higher diversity estimate of 0.27 compared to the Mount Kenya population (0.24). The broad diversity within Kenyan Pleurotus species suggests the potential for obtaining native strains suitable for commercial cultivation.
Mushroom and Pesto: A Match Made in Heaven?
You may want to see also
Explore related products

Oyster mushroom gene isolation and identification
Oyster mushrooms, belonging to the genus Pleurotus, are the second most grown mushrooms globally after shiitake. They are commercially cultivated worldwide, especially in developing countries, due to their ease of cultivation and high biological efficiency. The species Pleurotus cornucopiae is of particular gastronomic and nutritional value.
To improve the genetic qualities of oyster mushrooms, various breeding approaches are applied, including selection, hybridization, mutation breeding, molecular breeding, and genetic transformation. The selection of diverse parents producing basidiospores is key to successful hybridization. Single spore isolates (SSIs) selection is another important criterion for economically important characters such as yield.
To isolate and identify developmentally regulated genes during fruiting body development, cDNA libraries were constructed from eight developmental stages of the oyster mushroom, Pleurotus ostreatus. From these libraries, 11,761 expressed sequence tags (PoESTs) were generated, with 4060 different genes (PoUnigenes) identified, representing 34.5% of the entire genome. RT-PCR was used to confirm the specific expression of nine genes that showed specific redundancy in fruiting body stages, with four genes expressed specifically and others abundantly.
The identification of genes expressed during developmental stages is important for understanding the molecular mechanism of fruiting body development, which has commercial and scientific importance for the efficient production of edible mushrooms. Further genomic and genetic analyses of P. ostreatus will advance our understanding of this common edible mushroom.
Mushroom Hunting: Best Containers for Foraging
You may want to see also

Ancient oyster mushroom species and geographic speciation
Oyster mushrooms, belonging to the genus Pleurotus, are some of the most commonly cultivated edible mushrooms worldwide. They are also used for mycoremediation of pollutants like petroleum and polycyclic aromatic hydrocarbons. The oyster mushroom species P. ostreatus, for instance, can grow on and degrade oxo-biodegradable plastic bags and renewable polyethylene.
The classification of species within the genus Pleurotus is challenging due to high phenotypic variability across wide geographic ranges, geographic overlap of species, and ongoing evolution and speciation. Phylogenetic analysis of ribosomal DNA sequences has revealed ancient and recent patterns of geographic speciation in the oyster mushroom Pleurotus. Gene phylogenies were developed to examine the relationship between reproductive isolation, genetic divergence, and biogeography in oyster mushrooms (Pleurotus).
Analysis of sequence data from eight intersterility groups revealed an ancient origin for four intersterility groups with a broad geographic distribution (worldwide). In contrast, more recently evolved groups are restricted to the Northern Hemisphere. Further analysis using sequence data from the rDNA internal transcribed spacer region confirmed a pattern of genetic divergence associated with allopatric speciation among populations from different continents in the Northern Hemisphere.
The oyster mushroom species P. ostreatus, commonly known as the oyster or pearl oyster mushroom, is found in temperate and subtropical forests worldwide. It is a popular edible mushroom with a mild taste and a slight odour similar to anise. The classification of oyster mushrooms into different species is challenging due to their high phenotypic variability and geographic overlap. However, phylogenetic analysis of ribosomal DNA sequences has provided valuable insights into the ancient origins and geographic speciation patterns of oyster mushroom species.
Skinny Mushroom Secrets: Simple Preparation Techniques
You may want to see also
Frequently asked questions
Genetic isolation is when a genetically cohesive group of interbreeding individuals diverges into two or more genetically distinct groups.
Genetic isolation does occur in oyster mushrooms. Oyster mushrooms are known for their huge species and strain diversity, with 26 taxa documented in India as of 2017.
Genetic isolation in oyster mushrooms occurs through the process of speciation, which involves a hiatus in gene exchange between two groups, allowing them to accumulate genetic differences over time.
Factors such as geographic distribution, reproductive isolation, genetic divergence, and biogeography contribute to genetic isolation in oyster mushrooms.
Genetic isolation in oyster mushrooms has implications for their breeding and cultivation. It allows for the development of region-specific strains and the improvement of traits such as yield, fruit body quality, and resistance to stresses.

























